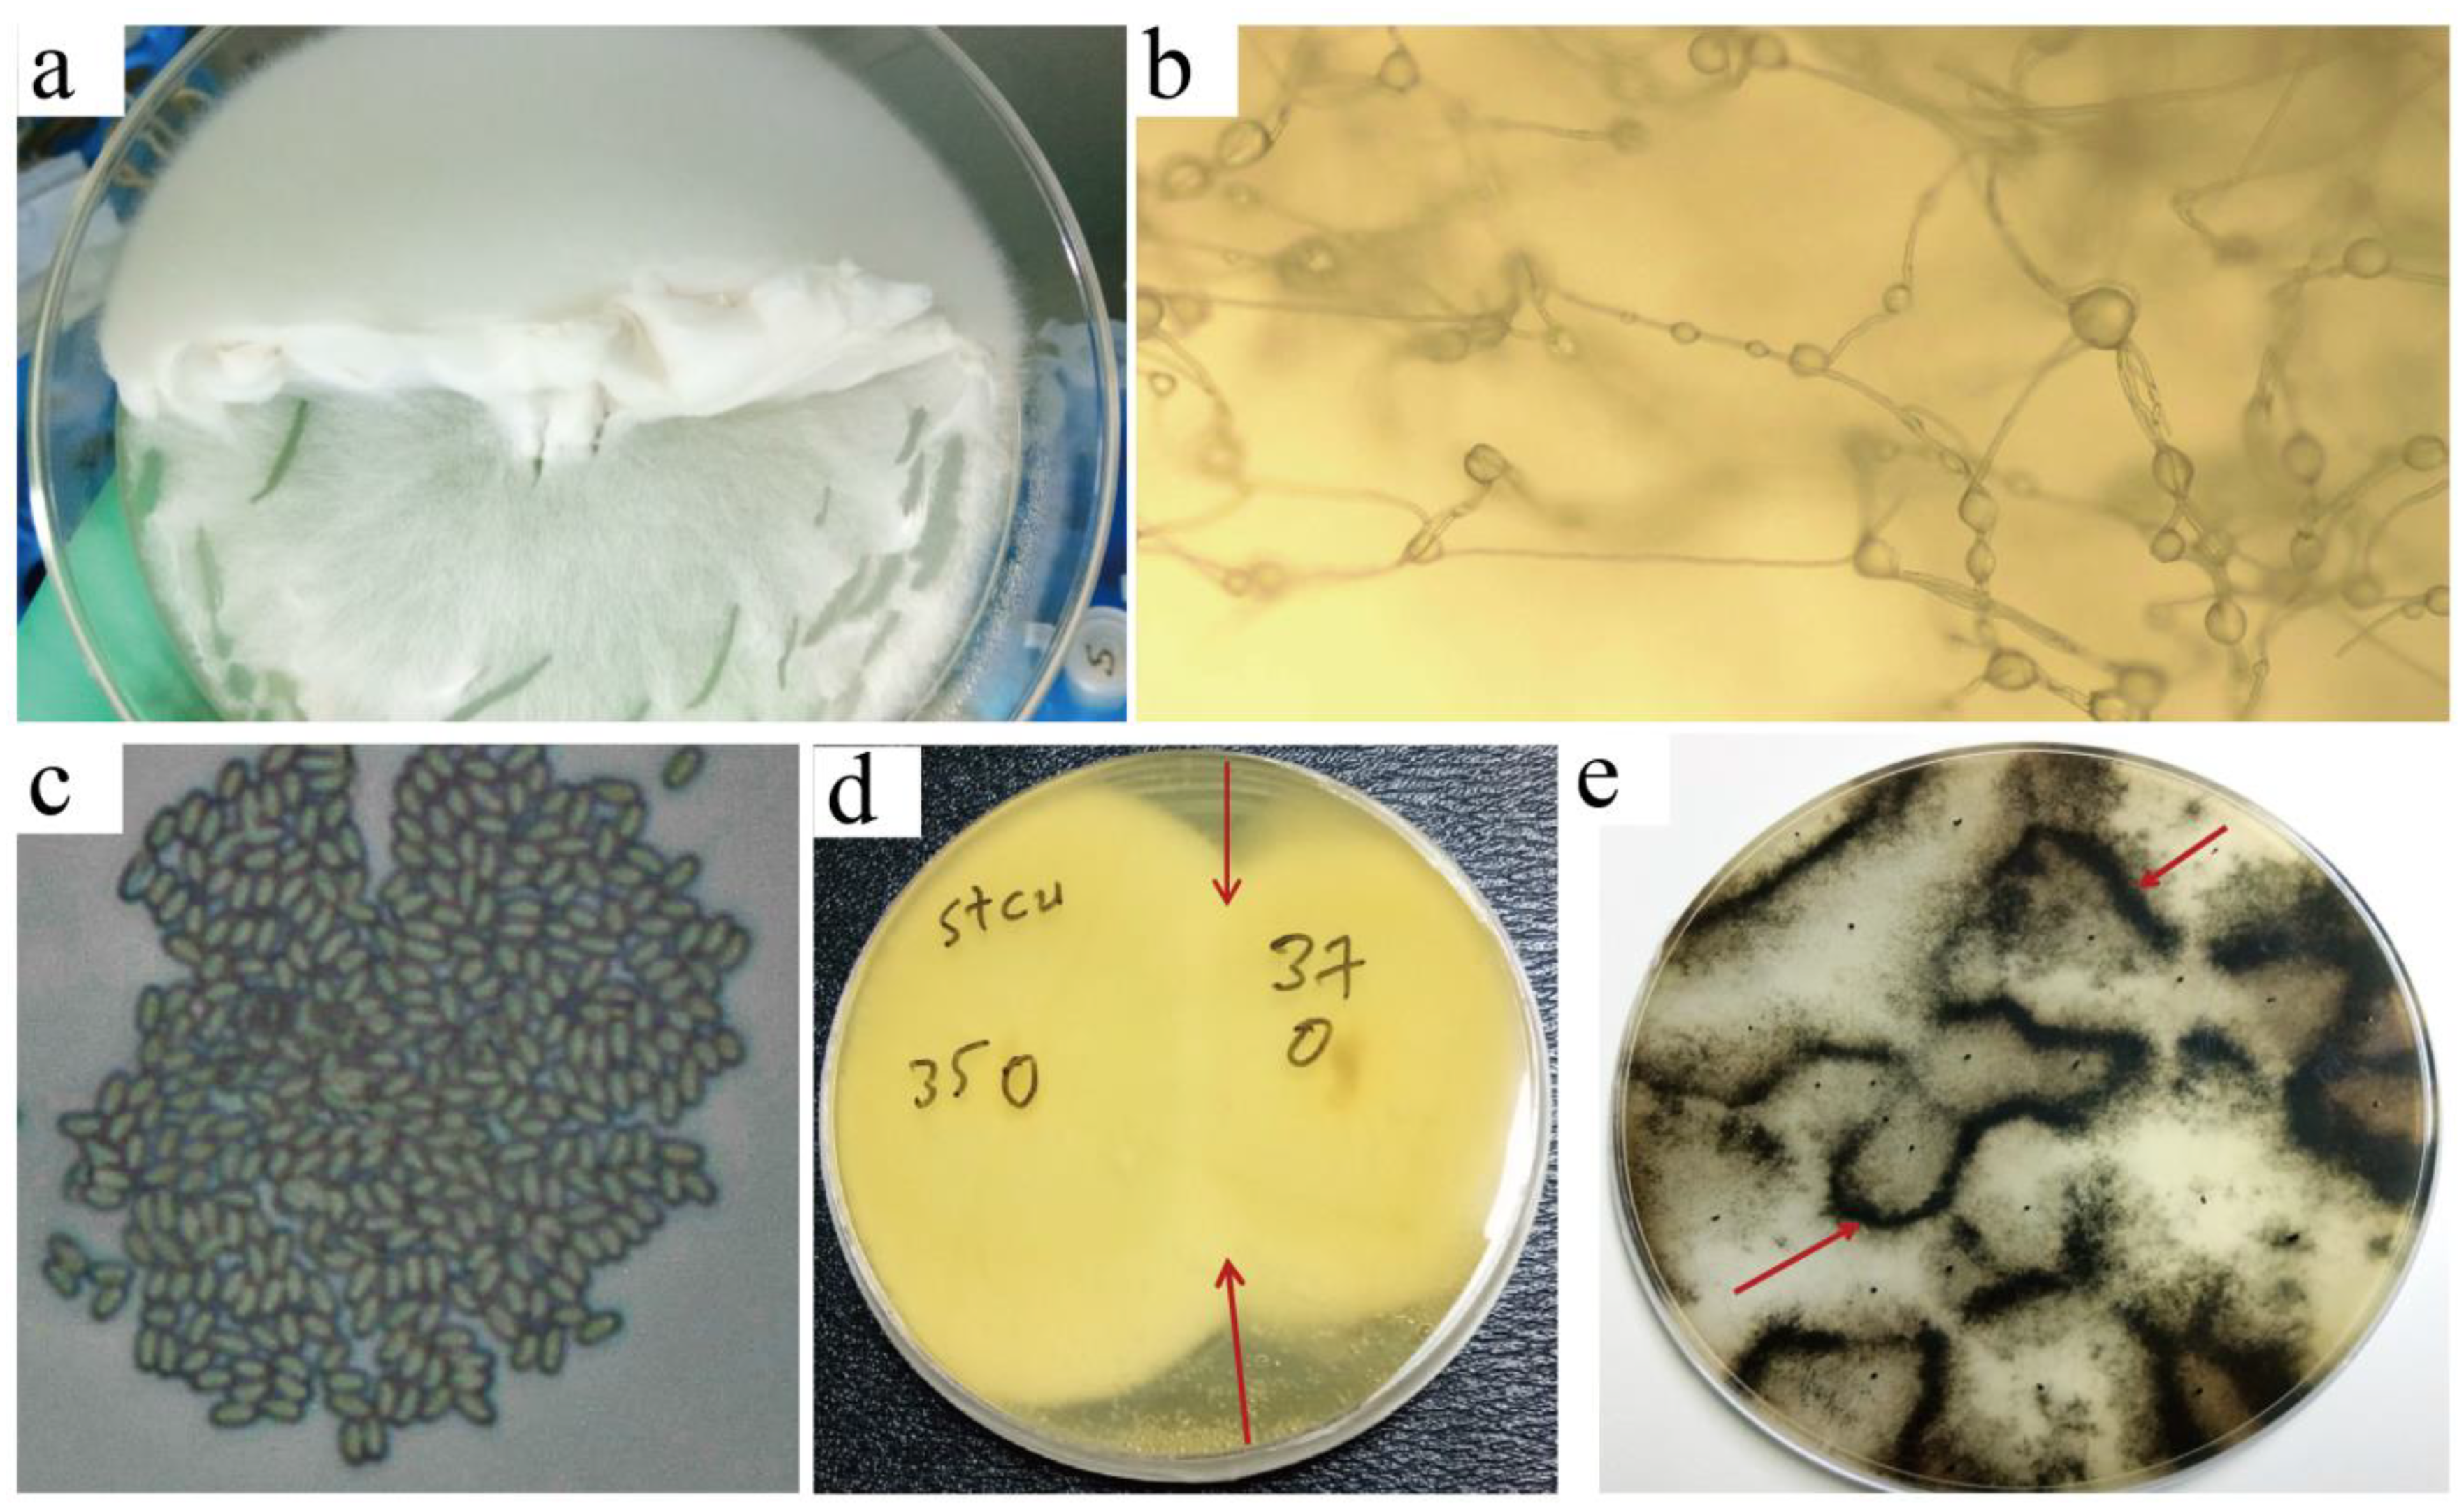
Microorganisms 10 02088 g006 Microorganisms 10 02088 g006

StcU-2 Gene Mutation via CRISPR/Cas9 Leads to Misregulation of Spore-Cyst Formation in Ascosphaera apis
Abstract
1. Introduction
2. Materials and Methods
2.1. Fungal Strain, and Culture Conditions
2.2. Determining Hygromycin B Antibiotic Resistance Level of Ascosphaera apis
2.3. Screening of the A. apis Target Gene to Be Edited
2.3.1. Primer Designing and Synthesis
2.3.2. Specific Target Gene Amplification
2.4. Establishment of the CRISPR/Cas9 for A. apis Gene Inactivation
2.4.1. Designing of Experimental sgRNA
2.4.2. Protoplast Isolation and Transformation of A. apis
2.4.3. Screening of Target Gene Edited A. apis Mutants, Mating Test, and Sporulation Verification
3. Results
3.1. Determination of Hygromycin B Resistance
3.2. Laser Scanning Microscopic Analysis of CRISPR/Cas9-Edited A. apis Mutant Colonies
3.3. PCR and Sequence Analysis of Transformants
3.4. Growth Observation and Sporulation of Mutants
4. Discussion
4.1. Successful Mutation of the StcU-2 Gene Inhibits A. apis Sporulation and Melanin Production, Which Provides an Effective Way to Control Diseases Caused by Ascosphaera
4.2. CRISPR/Cas9 Can Be Used for A. apis Gene Function Studies
4.3. Minimum Growth-Limiting Level of Hygromycin B Antibiotic to Wild-Strain A. apis Colonies Was Determined
5. Conclusions
Author Contributions
Funding
Institutional Review Board Statement
Informed Consent Statement
Data Availability Statement
Acknowledgments
Conflicts of Interest
References
- Aronstein, K.A.; Murray, K.D. Chalkbrood disease in honey bees. J. Invertebr. Pathol. 2010, 103, S20–S29. [Google Scholar] [CrossRef]
- Evison, S.E.F.; Jensen, A.B. The biology and prevalence of fungal diseases in managed and wild bees. Curr. Opin. Insect Sci. 2018, 26, 105–113. [Google Scholar] [CrossRef] [PubMed]
- Jensen, A.B.; Aronstein, K.; Flores, J.M.; Vojvodic, S.; Palacio, M.A.; Spivak, M. Standard methods for fungal brood disease research. J. Apicult. Res. 2013, 52, 1–20. [Google Scholar] [CrossRef] [PubMed]
- Evison, S.E.F. Chalkbrood: Epidemiological perspectives from the host-parasite relationship. Curr. Opin. Insect Sci. 2015, 10, 65–70. [Google Scholar] [CrossRef] [PubMed]
- Li, Z.G.; Hou, M.S.; Qiu, Y.M.; Zhao, B.; Nie, H.Y.; Su, S.K. Changes in Antioxidant Enzymes Activity and Metabolomic Profiles in the Guts of Honey Bee (Apis mellifera) Larvae Infected with Ascosphaera apis. Insects 2020, 11, 419. [Google Scholar] [CrossRef]
- Sevim, A.; Akpinar, R.; Karaoglu, S.A.; Bozdeveci, A.; Sevim, E. Prevalence and phylogenetic analysis of Ascosphaera apis (Maassen ex Claussen) LS Olive & Spiltoir (1955) isolates from honeybee colonies in Turkey. Biologia 2022. [Google Scholar] [CrossRef]
- Chen, H.Z.; Du, Y.; Zhu, Z.W.; Xiong, C.L.; Zheng, Y.Z.; Chen, D.F.; Guo, R. Transcriptome data of control and Ascosphaera apis infected Apis mellifera ligustica larval guts. Data Brief 2020, 29, 105264. [Google Scholar] [CrossRef]
- Guo, R.; Chen, D.F.; Diao, Q.Y.; Xiong, C.L.; Zheng, Y.Z.; Hou, C.S. Transcriptomic investigation of immune responses of the Apis cerana cerana larval gut infected by Ascosphaera apis. J. Invertebr. Pathol. 2019, 166, 107210. [Google Scholar] [CrossRef]
- Aronstein, K.A.; Murray, K.D.; Saldivar, E. Transcriptional responses in honey bee larvae infected with chalkbrood fungus. BMC Genom. 2010, 11, 391–403. [Google Scholar] [CrossRef]
- Krutmuang, P.; Rajula, J.; Pittarate, S.; Chatima, C.; Thungrabeab, M.; Mekchay, S.; Senthil-Nathan, S. The inhibitory action of plant extracts on the mycelial growth of Ascosphaera apis, the causative agent of chalkbrood disease in Honey bee. Toxicol. Rep. 2022, 9, 713–719. [Google Scholar] [CrossRef]
- Mraz, P.; Hybl, M.; Kopecky, M.; Bohata, A.; Konopicka, J.; Hostickova, I.; Konvalina, P.; Sipos, J.; Rost, M.; Curn, V. The Effect of Artificial Media and Temperature on the Growth and Development of the Honey Bee Brood Pathogen Ascosphaera apis. Biology 2021, 10, 431. [Google Scholar] [CrossRef] [PubMed]
- Xue, F.; Li, W.; Wubie, A.J.; Hu, Y.Y.; Guo, Z.B.; Zhou, T.; Xu, S.F. Biological control of Ascosphaera apis in honey bees using restricted enzyme mediated integration (REMI) transformed Trichoderma atroviride mutants. Biol. Control 2015, 83, 46–50. [Google Scholar] [CrossRef]
- Iorizzo, M.; Testa, B.; Ganassi, S.; Lombardi, S.J.; Ianiro, M.; Letizia, F.; Succi, M.; Tremonte, P.; Vergalito, F.; Cozzolino, A.; et al. Probiotic Properties and Potentiality of Lactiplantibacillus plantarum Strains for the Biological Control of Chalkbrood Disease. J. Fungi 2021, 7, 379. [Google Scholar] [CrossRef] [PubMed]
- Abrol, D.P. The Problem of Diseases in Bees. In Pollination Biology: Biodiversity Conservation and Agricultural Production; Springer: Dordrecht, The Netherlands, 2012. [Google Scholar] [CrossRef]
- Jensen, A.B.; Welker, D.L.; Kryger, P.; James, R.R. Polymorphic DNA sequences of the fungal honey bee pathogen Ascosphaera apis. FEMS Microbiol. Lett. 2012, 330, 17–22. [Google Scholar] [CrossRef]
- Qin, X.; Evans, J.D.; Aronstein, K.A.; Murray, K.D.; Weinstock, G.M. Genome sequences of the honey bee pathogens Paenibacillus larvae and Ascosphaera apis. Insect Mol. Biol. 2006, 15, 715–718. [Google Scholar] [CrossRef]
- Cornman, R.S.; Bennett, A.K.; Murray, K.D.; Evans, J.D.; Elsik, C.G.; Aronstein, K. Transcriptome analysis of the honey bee fungal pathogen, Ascosphaera apis: Implications for host pathogenesis. BMC Genom. 2012, 13, 285. [Google Scholar] [CrossRef]
- Keller, N.P.; Segner, S.; Bhatnagar, D.; Adams, T.H. Stcs, a Putative P-450 Monooxygenase, Is Required for the Conversion of Versicolorin-a to Sterigmatocystin in Aspergillus nidulans. Appl. Environ. Microb. 1995, 61, 3628–3632. [Google Scholar] [CrossRef]
- Sweeney, M.J.; Dobson, A.D.W. Molecular biology of mycotoxin biosynthesis. FEMS Microbiol. Lett. 1999, 175, 149–163. [Google Scholar] [CrossRef]
- Mahata, P.K.; Dass, R.S.; Gunti, L.; Thorat, P.A. First report on the metabolic characterization of Sterigmatocystin production by select Aspergillus species from the Nidulantes section in Foeniculum vulgare. Front. Microbiol. 2022, 13, 958424. [Google Scholar] [CrossRef]
- Rank, C.; Nielsen, K.F.; Larsen, T.O.; Varga, J.; Samson, R.A.; Frisvad, J.C. Distribution of sterigmatocystin in filamentous fungi. Fungal Biol. 2011, 115, 406–420. [Google Scholar] [CrossRef]
- Caceres, I.; Al Khoury, A.; El Khoury, R.; Lorber, S.; Oswald, I.P.; El Khoury, A.; Atoui, A.; Puel, O.; Bailly, J.-D. Aflatoxin Biosynthesis and Genetic Regulation: A Review. Toxins 2020, 12, 150. [Google Scholar] [CrossRef] [PubMed]
- Cary, J.W.; Ehrlich, K.C.; Bland, J.M.; Montalbano, B.G. The Aflatoxin Biosynthesis Cluster Gene, aflX, Encodes an Oxidoreductase Involved in Conversion of Versicolorin A to Demethylsterigmatocystin. Appl. Environ. Microb. 2006, 72, 1096–1101. [Google Scholar] [CrossRef] [PubMed]
- Nieto, C.H.D.; Granero, A.M.; Zon, M.A.; Fernandez, H. Sterigmatocystin: A mycotoxin to be seriously considered. Food Chem. Toxicol. 2018, 118, 460–470. [Google Scholar] [CrossRef]
- Varga, J.; Frisvad, J.C.; Samson, R.A. Two new aflatoxin producing species, and an overview of Aspergillus section Flavi. Stud. Mycol. 2011, 69, 57–80. [Google Scholar] [CrossRef] [PubMed]
- Liang, S.H.; Skory, C.D.; Linz, J.E. Characterization of the function of the ver-1A and ver-1B genes, involved in aflatoxin biosynthesis in Aspergillus parasiticus. Appl. Environ. Microb. 1996, 62, 4568–4575. [Google Scholar] [CrossRef]
- Pfannenstiel, B.T.; Zhao, X.; Wortman, J.; Wiemann, P.; Throckmorton, K.; Spraker, J.E.; Soukup, A.A.; Luo, X.; Lindner, D.L.; Lim, F.Y.; et al. Revitalization of a Forward Genetic Screen Identifies Three New Regulators of Fungal Secondary Metabolism in the Genus Aspergillus. mBio 2017, 8, e01246-17. [Google Scholar] [CrossRef] [PubMed]
- Keller, N.P.; Kantz, N.J.; Adams, T.H. Aspergillus nidulans verA Is Required for Production of the Mycotoxin Sterigmatocystin. Appl. Environ. Microb. 1994, 60, 1444–1450. [Google Scholar] [CrossRef]
- Butchko, R.A.E.; Adams, T.H.; Keller, N.P. Aspergillus nidulans mutants defective in stc gene cluster regulation. Genetics 1999, 153, 715–720. [Google Scholar] [CrossRef]
- Adams, T.H.; Yu, J.H. Coordinate control of secondary metabolite production and asexual sporulation in Aspergillus nidulans. Curr. Opin. Microbiol. 1998, 1, 674–677. [Google Scholar] [CrossRef]
- Zeng, H.; Cai, J.; Hatabayashi, H.; Nakagawa, H.; Nakajima, H.; Yabe, K. verA Gene is Involved in the Step to Make the Xanthone Structure of Demethylsterigmatocystin in Aflatoxin Biosynthesis. Int. J. Mol. Sci. 2020, 21, 6389. [Google Scholar] [CrossRef] [PubMed]
- Chettri, P.; Calvo, A.M.; Cary, J.W.; Dhingra, S.; Guo, Y.A.; McDougal, R.L.; Bradshaw, R.E. The veA gene of the pine needle pathogen Dothistroma septosporum regulates sporulation and secondary metabolism. Fungal Genet. Biol. 2012, 49, 141–151. [Google Scholar] [CrossRef] [PubMed]
- Tauber, J.P.; Einspanier, R.; Evans, J.D.; McMahon, D.P. Co-incubation of dsRNA reduces proportion of viable spores of Ascosphaera apis, a honey bee fungal pathogen. J. Apicult. Res. 2020, 59, 791–799. [Google Scholar] [CrossRef]
- Getachew, A.; Abejew, T.A.; Wu, J.L.; Xu, J.; Yu, H.M.; Tan, J.; Wu, P.J.; Tu, Y.Y.; Kang, W.P.; Wang, Z.; et al. Transcriptome profiling reveals insertional mutagenesis suppressed the expression of candidate pathogenicity genes in honeybee fungal pathogen, Ascosphaera apis. Sci. Rep. 2020, 10, 7532. [Google Scholar] [CrossRef] [PubMed]
- Getachew, A.; Wubie, A.J.; Wu, J.L.; Xu, J.; Wu, P.J.; Abejew, T.A.; Tu, Y.Y.; Zhou, T.; Xu, S.F. Molecular Identification of Pathogenicity Associated Genes in Honeybee Fungal Pathogen, Ascosphaera apis, by Restricted Enzyme-Mediated Integration (REMI) Constructed Mutants. Int. J. Agric. Biol. 2018, 20, 2879–2890. [Google Scholar]
- Doudna, J.A.; Charpentier, E. The new frontier of genome engineering with CRISPR-Cas9. Science 2014, 346, 1258096. [Google Scholar] [CrossRef]
- Al Abdallah, Q.; Ge, W.B.; Fortwendel, J.R. A Simple and Universal System for Gene Manipulation in Aspergillus fumigatus: In Vitro-Assembled Cas9-Guide RNA Ribonucleoproteins Coupled with Microhomology Repair Templates. mSphere 2017, 2, e00446-17. [Google Scholar] [CrossRef]
- Escobar-Aguirre, S.; Arancibia, D.; Escorza, A.; Bravo, C.; Andres, M.E.; Zamorano, P.; Martinez, V. Development of a Bicistronic Vector for the Expression of a CRISPR/Cas9-mCherry System in Fish Cell Lines. Cells 2019, 8, 75. [Google Scholar] [CrossRef]
- Bowling, S.; Sritharan, D.; Osorio, F.G.; Nguyen, M.; Cheung, P.; Rodriguez-Fraticelli, A.; Patel, S.; Yuan, W.C.; Fujiwara, Y.; Li, B.E.; et al. An Engineered CRISPR-Cas9 Mouse Line for Simultaneous Readout of Lineage Histories and Gene Expression Profiles in Single Cells. Cell 2020, 181, 1410–1422. [Google Scholar] [CrossRef] [PubMed]
- Liu, X.; Wu, S.R.; Xu, J.; Sui, C.; Wei, J.H. Application of CRISPR/Cas9 in plant biology. Acta Pharm. Sin. B 2017, 7, 292–302. [Google Scholar] [CrossRef]
- Casini, A.; Olivieri, M.; Petris, G.; Montagna, C.; Reginato, G.; Maule, G.; Lorenzin, F.; Prandi, D.; Romanel, A.; Demichelis, F.; et al. A highly specific SpCas9 variant is identified by in vivo screening in yeast. Nat. Biotechnol. 2018, 36, 265–271. [Google Scholar] [CrossRef]
- Fuller, K.K.; Chen, S.; Loros, J.J.; Dunlapa, J.C. Development of the CRISPR/Cas9 System for Targeted Gene Disruption in Aspergillus fumigatus. Eukaryot. Cell 2015, 14, 1073–1080. [Google Scholar] [CrossRef] [PubMed]
- Nakamura, H.; Katayama, T.; Okabe, T.; Iwashita, K.; Fujii, W.; Kitamoto, K.; Maruyama, J. Highly efficient gene targeting in Aspergillus oryzae industrial strains under ligD mutation introduced by genome editing: Strain-specific differences in the effects of deleting EcdR, the negative regulator of sclerotia formation. J. Gen. Appl. Microbiol. 2017, 63, 172–178. [Google Scholar] [CrossRef] [PubMed]
- Schuster, M.; Kahmann, R. CRISPR-Cas9 genome editing approaches in filamentous fungi and oomycetes. Fungal Genet. Biol. 2019, 130, 43–53. [Google Scholar] [CrossRef] [PubMed]
- Gu, S.Y.; Li, J.G.; Chen, B.C.; Sun, T.; Liu, Q.; Xiao, D.G.; Tian, C.G. Metabolic engineering of the thermophilic filamentous fungus Myceliophthora thermophila to produce fumaric acid. Biotechnol. Biofuels 2018, 11, 323. [Google Scholar] [CrossRef]
- Pitt, J.I.; Hocking, A.D. Fungi and Food Spoilage, 3rd ed.; Springer Dordrecht/Heidelberg: London, OR, USA, 2009; pp. 1–519. [Google Scholar]
- Knight, C.J.; Bailey, A.M.; Foster, G.D. Agrobacterium-Mediated Transformation of the Plant Pathogenic Fungus Verticillium Albo-Atrum. J. Plant. Pathol. 2009, 91, 745–750. [Google Scholar]
- Tunlid, A.; Ahman, J.; Oliver, R.P. Transformation of the nematode-trapping fungus Arthrobotrys oligospora. FEMS Microbiol. Lett. 1999, 173, 111–116. [Google Scholar] [CrossRef] [PubMed]
- Nodvig, C.S.; Nielsen, J.B.; Kogle, M.E.; Mortensen, U.H. A CRISPR-Cas9 System for Genetic Engineering of Filamentous Fungi. PLoS ONE 2015, 10, e0133085. [Google Scholar] [CrossRef]
- Wubie, A.J.; Hu, Y.; Li, W.; Huang, J.; Guo, Z.; Xu, S.; Zhou, T. Factors Analysis in Protoplast Isolation and Regeneration from a Chalkbrood Fungus, Ascosphaera apis. Int. J. Agric. Biol. 2014, 16, 89–96. [Google Scholar]
- Pohl, C.; Kiel, J.A.K.W.; Driessen, A.J.M.; Bovenberg, R.A.L.; Nygard, Y. CRISPR/Cas9 Based Genome Editing of Penicillium chrysogenum. Acs. Synth. Biol. 2016, 5, 754–764. [Google Scholar] [CrossRef]
- Daugelaite, J.; O’ Driscoll, A.; Sleator, R.D. An Overview of Multiple Sequence Alignments and Cloud Computing in Bioinformatics. ISRN Biomath. 2013, 2013, 1–14. [Google Scholar] [CrossRef]
- Thompson, J.D.; Higgins, D.G.; Gibson, T.J. CLUSTAL W: Improving the sensitivity of progressive multiple sequence alignment through sequence weighting, position-specific gap penalties and weight matrix choice. Nucleic Acids Res. 1994, 22, 4673–4680. [Google Scholar] [CrossRef] [PubMed]
- Tapia-Gonzalez, J.M.; Alcazar-Oceguera, G.; Macias-Macias, J.O.; Contreras-Escareno, F.; Tapia-Rivera, J.C.; Petukhova, T.; Guzman-Novoa, E. Ascospherosis in honey bees and its relationship to environmental factors in Jalisco, Mexico. Rev. Mex. Cienc. Pecu. 2020, 11, 468–478. [Google Scholar] [CrossRef]
- Reybroeck, W.; Daeseleire, E.; de Brabander, H.F.; Herman, L. Antimicrobials in beekeeping. Vet. Microbiol. 2012, 158, 1–11. [Google Scholar] [CrossRef] [PubMed]
- Ansari, M.J.; Al-Ghamdi, A.; Usmani, S.; Khan, K.A.; Alqarni, A.S.; Kaur, M.; Al-Waili, N. In vitro evaluation of the effects of some plant essential oils on Ascosphaera apis, the causative agent of Chalkbrood disease. Saudi J. Biol. Sci. 2017, 24, 1001–1006. [Google Scholar] [CrossRef] [PubMed]
- Iorizzo, M.; Lombardi, S.J.; Ganassi, S.; Testa, B.; Ianiro, M.; Letizia, F.; Succi, M.; Tremonte, P.; Vergalito, F.; Cozzolino, A.; et al. Antagonistic Activity against Ascosphaera apis and Functional Properties of Lactobacillus kunkeei Strains. Antibiotics 2020, 9, 262. [Google Scholar] [CrossRef]
- Vojvodic, S.; Boomsma, J.J.; Eilenberg, J.; Jensen, A.B. Virulence of mixed fungal infections in honey bee brood. Front. Zool. 2012, 9, 5. [Google Scholar] [CrossRef]
- Klinger, E.G.; Vojvodic, S.; DeGrandi-Hoffman, G.; Welker, D.L.; James, R.R. Mixed infections reveal virulence differences between host-specific bee pathogens. J. Invertebr. Pathol. 2015, 129, 28–35. [Google Scholar] [CrossRef]
- Garrido-Bailon, E.; Higes, M.; Martinez-Salvador, A.; Antunez, K.; Botias, C.; Meana, A.; Prieto, L.; Martin-Hernandez, R. The prevalence of the honeybee brood pathogens Ascosphaera apis, Paenibacillus larvae and Melissococcus plutonius in Spanish apiaries determined with a new multiplex PCR assay. Microb. Biotechnol. 2013, 6, 731–739. [Google Scholar] [CrossRef] [PubMed]
- Jensen, A.B.; Pedersen, B.V.; Eilenberg, J. Differential susceptibility across honey bee colonies in larval chalkbrood resistance. Apidologie 2009, 40, 524–534. [Google Scholar] [CrossRef]
- Vojvodic, S.; Jensen, A.B.; Markussen, B.; Eilenberg, J.; Boomsma, J.J. Genetic Variation in Virulence among Chalkbrood Strains Infecting Honeybees. PLoS ONE 2011, 6, e25035. [Google Scholar] [CrossRef] [PubMed]
- Wynns, A.A.; Jensen, A.B.; Eilenberg, J.; James, R. Ascosphaera subglobosa, a new spore cyst fungus from North America associated with the solitary bee Megachile rotundata. Mycologia 2012, 104, 108–114. [Google Scholar] [CrossRef] [PubMed]
- Pitts-Singer, T.L.; Cane, J.H. The Alfalfa Leafcutting Bee, Megachile rotundata: The World’s Most Intensively Managed Solitary Bee. Annu. Rev. Entomol. 2011, 56, 221–237. [Google Scholar] [CrossRef] [PubMed]
- Flores, J.M.; Spivak, M.; Gutierrez, I. Spores of Ascosphaera apis contained in wax foundation can infect honeybee brood. Vet. Microbiol. 2005, 108, 141–144. [Google Scholar] [CrossRef] [PubMed]
- Boomsma, J.J.; Jensen, A.B.; Meyling, N.V.; Eilenberg, J. Evolutionary Interaction Networks of Insect Pathogenic Fungi. Annu. Rev. Entomol. 2014, 59, 467–485. [Google Scholar] [CrossRef]
- Deng, S.; Yao, C.F.; Zhang, X.; Jia, Z.Z.; Shan, C.Y.; Luo, X.Y.; Lin, L. Involvement of UDP-glucose pyrophosphorylase from Verticillium dahliae in cell morphogenesis, stress responses, and host infection. Fungal Biol. 2020, 124, 648–660. [Google Scholar] [CrossRef]
- Son, Y.E.; Cho, H.J.; Chen, W.P.; Son, S.H.; Lee, M.K.; Yu, J.H.; Park, H.S. The role of the VosA-repressed dnjA gene in development and metabolism in Aspergillus species. Curr. Genet. 2020, 66, 621–633. [Google Scholar] [CrossRef]
- Hernandez-Chavez, M.J.; Perez-Garcia, L.A.; Nino-Vega, G.A.; Mora-Montes, H.M. Fungal Strategies to Evade the Host Immune Recognition. J. Fungi 2017, 3, 51. [Google Scholar] [CrossRef]
- Nosanchuk, J.D.; Casadevall, A. The contribution of melanin to microbial pathogenesis. Cell. Microbiol. 2003, 5, 203–223. [Google Scholar] [CrossRef]
- Li, Z.; Heng, H.; Qin, Q.; Chen, L.; Wang, Y.; Zhou, Z. Physicochemical properties, molecular structure, antioxidant activity, and biological function of extracellular melanin from Ascosphaera apis. J. Zhejiang Univ. Sci. B 2022, 23, 365–381. [Google Scholar] [CrossRef]
- Jensen, A.B.; James, R.R.; Eilenberg, J. Long-term storage of Ascosphaera aggregata and Ascosphaera apis, pathogens of the leafcutting bee (Megachile rotundata) and the honey bee (Apis mellifera). J. Invertebr. Pathol. 2009, 101, 157–160. [Google Scholar] [CrossRef]
- Chen, D.F.; Du, Y.; Fan, X.X.; Zhu, Z.W.; Jiang, H.B.; Wang, J.; Fan, Y.C.; Chen, H.Z.; Zhou, D.D.; Xiong, C.L.; et al. Reconstruction and functional annotation of Ascosphaera apis full-length transcriptome utilizing PacBio long reads combined with Illumina short reads. J. Invertebr. Pathol. 2020, 176, 107475. [Google Scholar] [CrossRef] [PubMed]
- Adli, M. The CRISPR tool kit for genome editing and beyond. Nat. Commun. 2018, 9, 1911. [Google Scholar] [CrossRef] [PubMed]
- Mali, P.; Aach, J.; Stranges, P.B.; Esvelt, K.M.; Moosburner, M.; Kosuri, S.; Yang, L.H.; Church, G.M. CAS9 transcriptional activators for target specificity screening and paired nickases for cooperative genome engineering. Nat. Biotechnol. 2013, 31, 833–838. [Google Scholar] [CrossRef]
- Boettcher, M.; McManus, M.T. Choosing the Right Tool for the Job: RNAi, TALEN, or CRISPR. Mol. Cell 2015, 58, 575–585. [Google Scholar] [CrossRef] [PubMed]
- Reber, S.; Mechtersheimer, J.; Nasif, S.; Benitez, J.A.; Colombo, M.; Domanski, M.; Jutzi, D.; Hedlund, E.; Ruepp, M.D. CRISPR-Trap: A clean approach for the generation of gene knockouts and gene replacements in human cells. Mol. Biol. Cell 2018, 29, 75–83. [Google Scholar] [CrossRef]
- Sugimoto, N.; Takakura, Y.; Shiraki, K.; Honda, S.; Takaya, N.; Hoshino, T.; Nakamura, A. Directed Evolution for Thermostabilization of a Hygromycin B Phosphotransferase from Streptomyces hygroscopicus. Biosci. Biotechnol. Biochem. 2013, 77, 2234–2241. [Google Scholar] [CrossRef] [PubMed][Green Version]
- Nakamura, A.; Takakura, Y.; Sugimoto, N.; Takaya, N.; Shiraki, K.; Hoshino, T. Enzymatic analysis of a thermostabilized mutant of an Escherichia coli hygromycin B phosphotransferase. Biosci. Biotechnol. Biochem. 2008, 72, 2467–2471. [Google Scholar] [CrossRef] [PubMed]

| Type of Gene | Forward Primer (F) | Reverse Primer (R) | Band Size |
|---|---|---|---|
| EGFP | GCTGACCCTGAAGTTCATCTG | CACCTTGATGCCGTTCTTCT | 367 bp |
| hph | GATATGTCCTGCGGGTAAA | CCGTCAACCAAGCTCTGATA | 710 bp |
| StcU-2 | GTCGGCTGTCAAGTTCCTCA | AGACCCTGACGCAGAACAAG | 613 bp |
Publisher’s Note: MDPI stays neutral with regard to jurisdictional claims in published maps and institutional affiliations. |
© 2022 by the authors. Licensee MDPI, Basel, Switzerland. This article is an open access article distributed under the terms and conditions of the Creative Commons Attribution (CC BY) license (https://creativecommons.org/licenses/by/4.0/).
Share and Cite
Aynalem, T.; Meng, L.; Getachew, A.; Wu, J.; Yu, H.; Tan, J.; Li, N.; Xu, S. StcU-2 Gene Mutation via CRISPR/Cas9 Leads to Misregulation of Spore-Cyst Formation in Ascosphaera apis. Microorganisms 2022, 10, 2088. https://doi.org/10.3390/microorganisms10102088
Aynalem T, Meng L, Getachew A, Wu J, Yu H, Tan J, Li N, Xu S. StcU-2 Gene Mutation via CRISPR/Cas9 Leads to Misregulation of Spore-Cyst Formation in Ascosphaera apis. Microorganisms. 2022; 10(10):2088. https://doi.org/10.3390/microorganisms10102088
Chicago/Turabian StyleAynalem, Tessema, Lifeng Meng, Awraris Getachew, Jiangli Wu, Huimin Yu, Jing Tan, Nannan Li, and Shufa Xu. 2022. "StcU-2 Gene Mutation via CRISPR/Cas9 Leads to Misregulation of Spore-Cyst Formation in Ascosphaera apis" Microorganisms 10, no. 10: 2088. https://doi.org/10.3390/microorganisms10102088
APA StyleAynalem, T., Meng, L., Getachew, A., Wu, J., Yu, H., Tan, J., Li, N., & Xu, S. (2022). StcU-2 Gene Mutation via CRISPR/Cas9 Leads to Misregulation of Spore-Cyst Formation in Ascosphaera apis. Microorganisms, 10(10), 2088. https://doi.org/10.3390/microorganisms10102088

